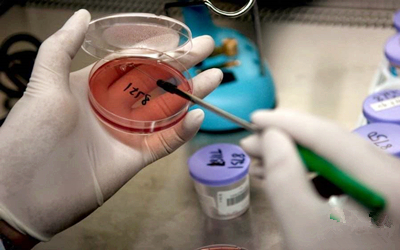

随着科学技术的越来越发达,基因概念慢慢走近千家万户,为人们所了解认识。最初,我们在生物课本上发现了转基因动物的诞生,而后转基因食品进入超市,引发诸多争议。

对于转基因(Transgene technology) 的利弊,其实无法一言定胜负,转基因对人类生活而言是一把双刃剑。一方面,在人们还不清楚了解转基因的来弄去脉,转入细菌基因的作物和西药[western medicine] 为大多数人所拒绝。也确实,转基因通过基因漂流影响着其他物种,对生物多样性构成极大的威胁,转基因食品也容易产生过敏反应。另一方面,我们无法否认的是转基因带来了生物领域的大变革,颠覆了人们对基因的陈旧看法,为全球繁衍和移植打开了新思路,此外,还节约生产成本,解决了粮食短缺问题。


一共有人参与 条评论

新华网:这里存在一个利益链吗? 彭光谦:西方有关转基因公司为了打开中国大门,在中国进行了什么样的公关活动,花了多少代价,目前我们不得而知。仅“十二五”期间,我国有关部门对转基因品种的研发拨款高达创纪录的300亿元,这是同期常规育种经费1.8亿的166倍。 在巨大的利益驱动下,全国农业科研部门对转基因项目趋之若鹜,形成一边倒的态势。支持转基因就有课题、有经费、有名、有利;不支持转基因就无课题、无经费,甚至遭到打压、威胁。中国毕竟是一个有几千年历史的传统农业大国,保护、发展、提升中国的生态农业水平,是实现民族繁荣富强的题中应有之义。我不知道为什么有关部门如此厚此薄彼,扶洋抑中,爱憎分明。
 (0)
(0)
怨言怨恨怨天尤人都没有用,只有以积极的心态面对当前的局面才是唯一的出路。那些靠耍嘴皮子的流量客就多积点德吧。三年了都顶过来了,现在最后关头更要团结一致,同心协力度过新冠疫情难关才是。
 (1)
(1)
女人早上起来的时候,乳房很敏感,男人阴茎会勃起,也叫晨勃反应。一般男人到了十几二十岁都会有正常反应,到了五六十岁就没有了。因为它表示着你体内的阳气充足。如果你在吃降血压、降血醣的药,或是降胆固醇、降甘油三脂的药,反正举凡任何属于降什么什么的西药,你只要开始吃,那就一定会导致早晨的阳事不举。再如,不管什么病找医生治疗、吃药,如果越来越阳萎了,晨勃反应也没有了,这样的药,就千万不要再继续服用了。
 (0)
(0)
傳統古風:1、小病治成大病。如:胆结石手术摘除后,由于没有从根本上解决体内结石形成的原因,所以再生的结石只能长在肝管內,结果病人有最初的胆结石病,治成肝结石病。2、西药的毒副作用所造成的损害,往往超过其治疗作用,结果使许多慢性疾病在治疗过程中,原发疾病未治好,而由于药物的毒副作用却又造成更多的疾病,甚至这些疾病的严重性超过原发疾病,如:慢性肾炎,再生障碍性贫血等。由于激素的应用原发病丝毫不可能治好,长期服用这些药,却导致了病人诸如:骨质疏松、高血黏度、男性化、自身免疫力降低、肥胖症、满月脸、性功能障碍……等等。3、更甚者,有些西药的毒副作用是潜伏十几年甚至是隔代发作的。如:二十世纪六十年代四环素牙事件,造成了那个时代的人们,十几年后要承受一辈子黑牙面对世界窘况;又如二十世纪七八十年代风靡一时的无痛分娩,造成了下一代女婴子宫癌发病率高出常人4-5倍的痛苦……等等。4、现在西医在临床上尤其是内科系统,如果你稍微留心观察便知,到底是哪一种真正的病能被治好呢?哪一个内科的病人不是常年反复的治疗,反复的住院~出院~住院~死亡。医院除了赚取病人的钱财,真正能给病人带来哪些健康呢??事实上,病人为了满足医院规定的“八大率”,大部分病人是入院和出院时的病情相差无几,甚至有的病人的病情还要重于入院时。5、西医学发展到二十一世纪的今天,给人一个似乎一个很发达很现代化的假象,可稍有一些医学知识的人都会知道,诸如:病毒性疾病,遗传性疾病,免疫性疾病,内分泌性疾病,神经系统疾病及多脏器疾病,等等,这些真正的疾病,哪一种是西医学能够真正解决的呢?所以我不得不提出,这个医学理论的科学性到底存在几分?它很可能已经把人类与疾病作斗争的思路引向歧途。
 (0)
(0)   1 1   共4条信息
共4条信息 |

  1 1   共1条信息
共1条信息 |